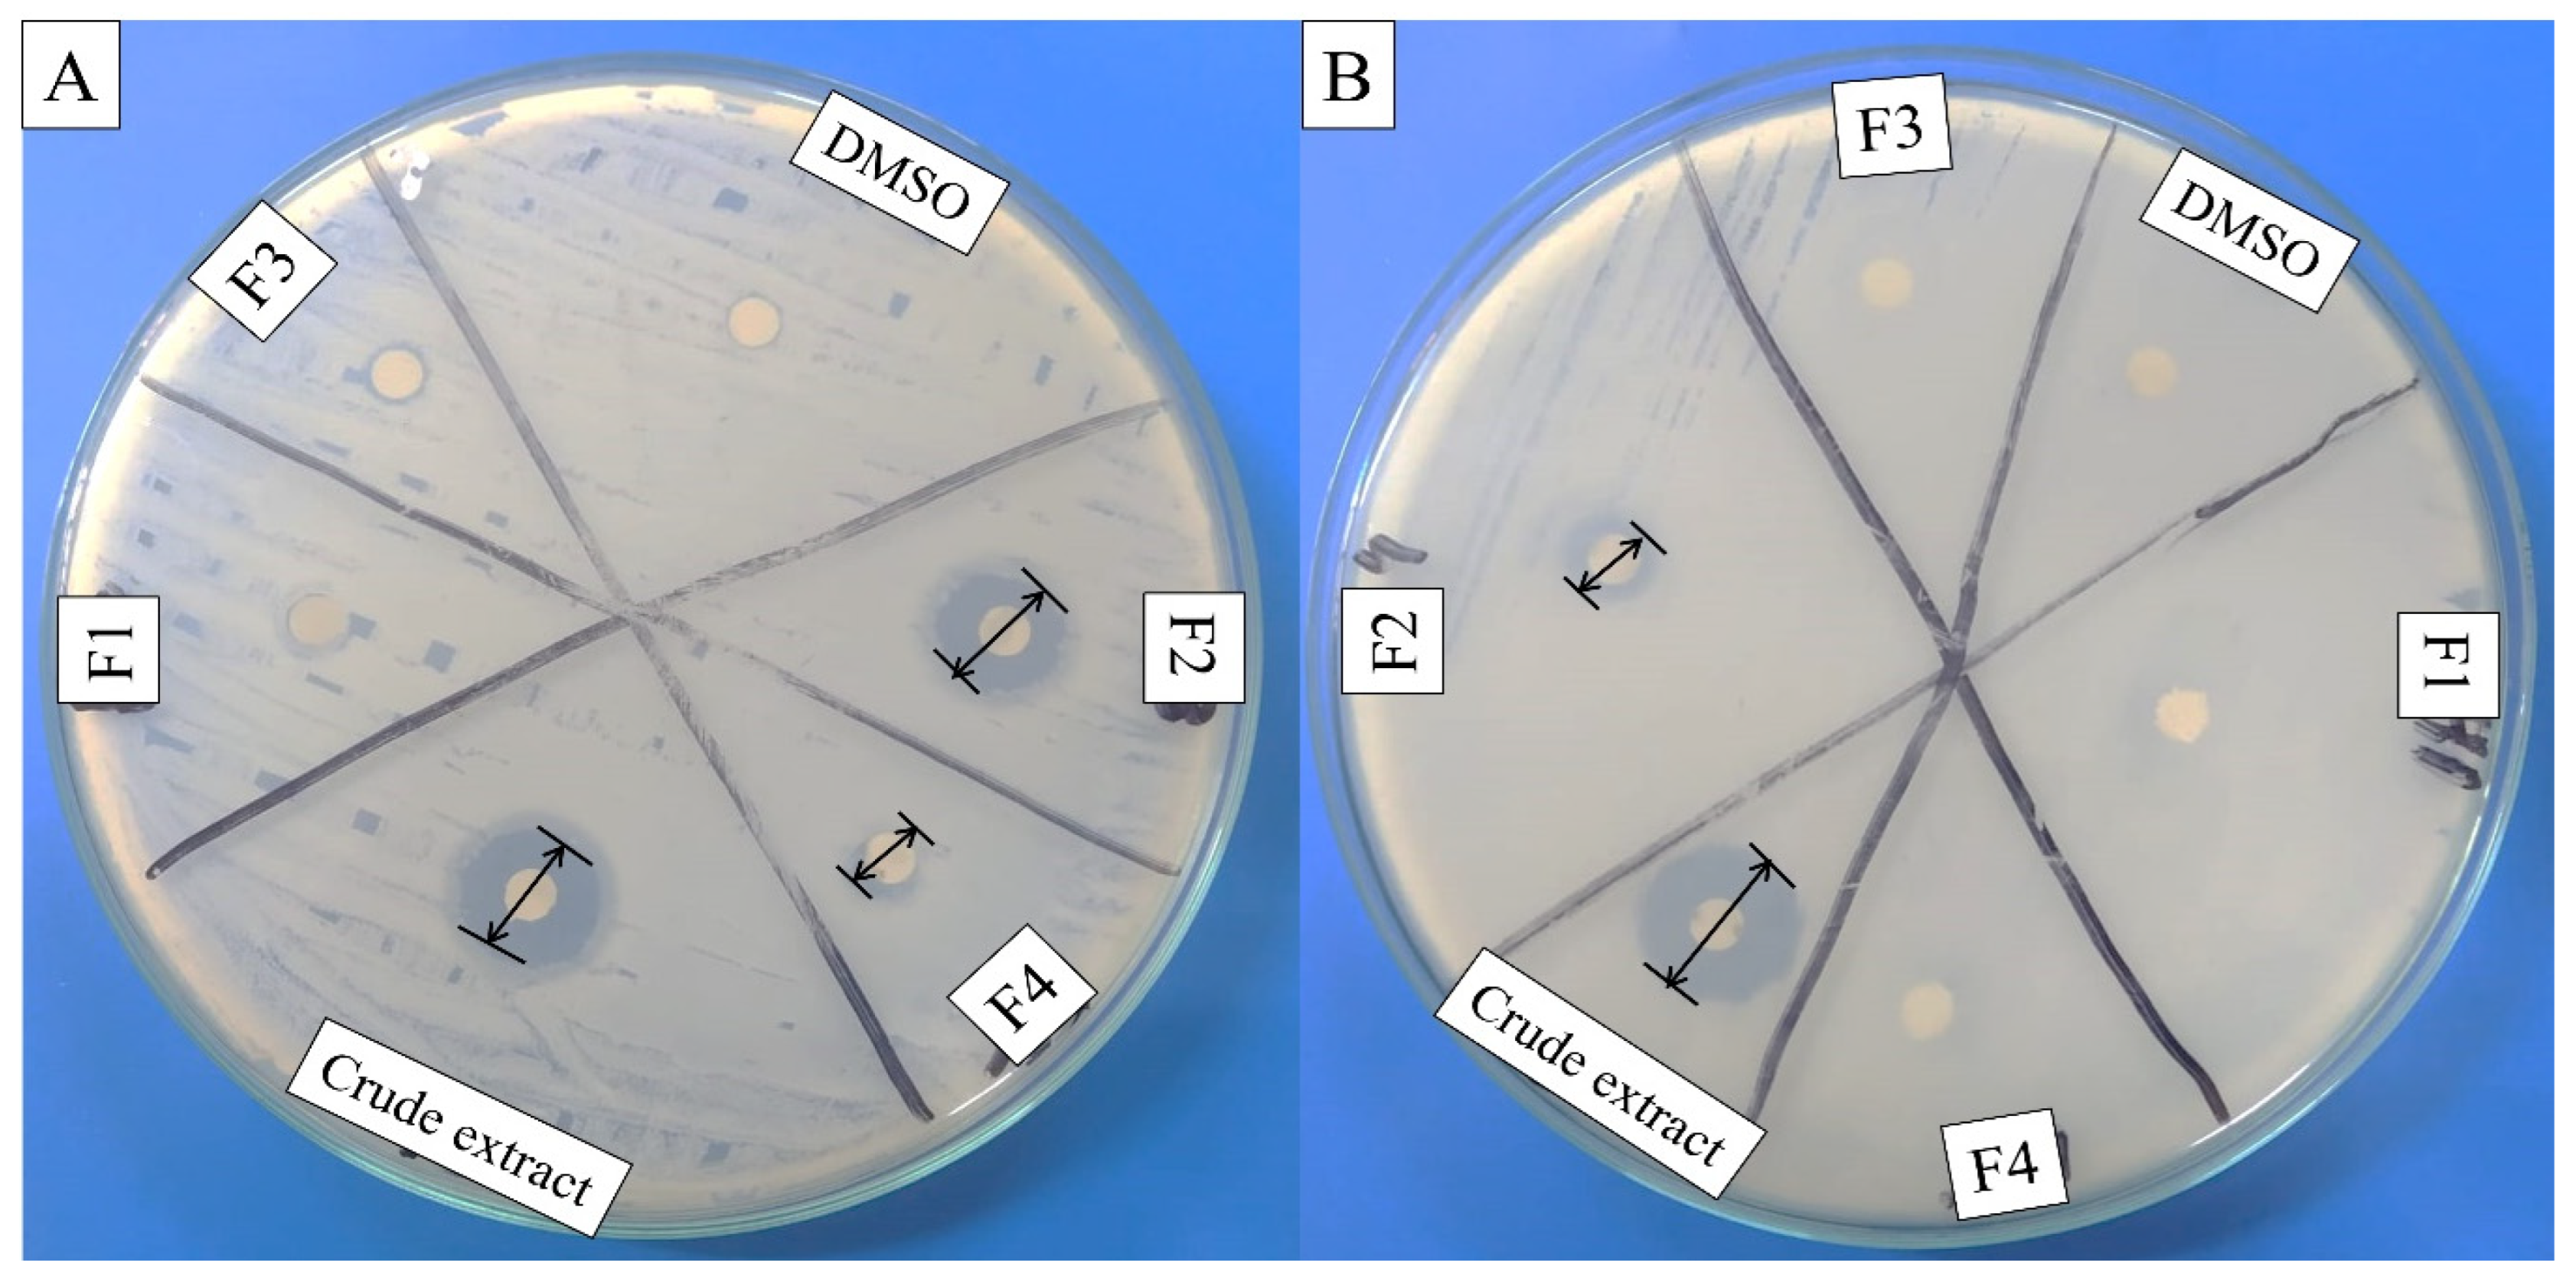
Molecules 27 07220 g002

The Antibacterial and Larvicidal Potential of Bis-(2-Ethylhexyl) Phthalate from Lactiplantibacillus plantarum
Abstract
1. Introduction
2. Results
2.1. Antibacterial Assay of Crude and Purified Metabolites
2.2. Structural Determination of Bioactive Metabolite
2.2.1. FT-IR Analysis
2.2.2. GC-MS Analysis
2.2.3. ESI-MS/MS Analysis
2.3. Mortality of Culex quinquefasciatus Larvae
2.4. Acetylcholinesterase (AChE) Enzyme Inhibitory Activity
2.5. Comet Assay
3. Discussion
4. Materials and Methods
4.1. Reagents and Chemicals
4.2. Bacterial Strains and Growth Conditions
4.3. Collection and Rearing of Culex quinquefasciatus
4.4. Fermentation Production of Secondary Metabolites
4.5. Antibacterial Activity Assay
4.6. Extraction and Purification of Bioactive Metabolites
4.7. Antibacterial Activity of Crude Extract and Fractions
4.8. Structure Determination of Bioactive Metabolite
4.8.1. Fourier Transform Infrared Spectroscopy (FT-IR)
4.8.2. Gas Chromatography-Mass Spectrometry (GC-MS)
4.8.3. Electrospray Ionization Mass Spectrometry (ESI-MS/MS) Analysis
4.9. Larvicidal Bioassay
4.10. Acetylcholinesterase Enzyme Assay
4.10.1. Homogenate Preparation
4.10.2. Quantitative Determination of Acetylcholinesterase (AChE) Activity
4.11. Comet Assay
4.12. Data Analysis
5. Conclusions
Author Contributions
Funding
Institutional Review Board Statement
Informed Consent Statement
Data Availability Statement
Acknowledgments
Conflicts of Interest
Sample Availability
References
- Hassan, S.W.M.; El Sersy, N.A.; Abdelwahab, A.E.S.; Ali, M.A.R. Statistical optimization and valuable applications of bioactive compounds produced by marine Pseudoalteromonas piscicida. J. Appl. Pharm. Sci. 2017, 7, 84–93. [Google Scholar]
- Zhou, L.; Feng, S.; Sun, G.; Tang, B.; Zhu, X.; Song, K.; Zhang, X.; Lu, H.; Liu, H.; Sun, Z. Extensively drug-resistant Gram-negative bacterial bloodstream infection in hematological disease. Infect. Drug Resist. 2019, 12, 481. [Google Scholar] [CrossRef]
- Habib, M.R.; Karim, M.R. Antimicrobial and cytotoxic activity of di-(2-ethylhexyl) phthalate and anhydrosophoradiol-3-acetate isolated from Calotropis gigantea (Linn.) flower. Mycobiology 2009, 37, 31–36. [Google Scholar] [CrossRef]
- Elumalai, D.; Hemalatha, P.; Kaleena, P. Larvicidal activity and GC–MS analysis of Leucas aspera against Aedes aegypti Anopheles stephensi and Culex quinquefasciatus. J. Saudi Soc. Agric. Sci. 2017, 16, 306–313. [Google Scholar] [CrossRef]
- Elumalai, D.; Kayalvizhi, M.; Kaleena, P.K.; Vignesh, A.; Hemavathi, M. Gas chromatography mass spectrometry analysis and larvicidal activity of leaf essential oil extract of Leucas aspera against dengue, malaria and filariasis vectors. J. Basic Appl. Zool. 2018, 79, 49. [Google Scholar] [CrossRef]
- Karthikeyan, V.; Sivakumar, K.; Gokuldas, A.; Mohanasundaram, S. Studies on larvicidal activity of Leucas aspera, Vitex negundo and eucalyptus against Culex quinquefasciatus collected from Cooum river of Chennai, India. Asian J. Pharm. Clin. Res. 2012, 5, 189–192. [Google Scholar]
- Govindarajan, M.; Mathivanan, T.; Elumalai, K.; Krishnappa, K.; Anandan, A. Mosquito larvicidal, ovicidal, and repellent properties of botanical extracts against Anopheles stephensi, Aedes aegypti, and Culex quinquefasciatus (Diptera: Culicidae). Parasitol. Res. 2011, 109, 353–367. [Google Scholar] [CrossRef]
- Benelli, G.; Romano, D. Mosquito vectors of Zika virus. Entomol. Gen. 2017, 36, 309–318. [Google Scholar] [CrossRef]
- Sánchez-Gómez, S.; Pagán, R.; Pavela, R.; Mazzara, E.; Spinozzi, E.; Marinelli, O.; Zeppa, L.; Morshedloo, M.R.; Maggi, F.; Canale, A. Lethal and sublethal effects of essential oil-loaded zein nanocapsules on a zoonotic disease vector mosquito, and their non-target impact. Ind. Crops Prod. 2022, 176, 114413. [Google Scholar] [CrossRef]
- Chen, X.B.; Liu, X.C.; Zhou, L.; Liu, Z.L. Essential oil composition and larvicidal activity of Clinopodium gracile (Benth) Matsum (Labiatae) aerial parts against the Aedes albopictus mosquito. Trop. J. Pharm. Res. 2013, 12, 799–804. [Google Scholar] [CrossRef]
- Zulhussnain, M.; Zahoor, M.K.; Rizvi, H.; Zahoor, M.A.; Rasul, A.; Ahmad, A.; Majeed, H.N.; Rasul, A.; Ranian, K.; Jabeen, F. Insecticidal and genotoxic effects of some indigenous plant extracts in Culex quinquefasciatus Say mosquitoes. Sci. Rep. 2020, 10, 6826. [Google Scholar] [CrossRef] [PubMed]
- Kamaraj, C.; Rahuman, A.A.; Bagavan, A. Antifeedant and larvicidal effects of plant extracts against Spodoptera litura (F.), Aedes aegypti L. and Culex quinquefasciatus Say. Parasitol. Res. 2008, 103, 325–331. [Google Scholar] [CrossRef]
- Joel, E.L.; Bhimba, B.V. A secondary metabolite with antibacterial activity produced by mangrove foliar fungus Schizophyllum commune. Int. J. Chem. Environ. Biol. Sci. 2013, 1, 2320–4087. [Google Scholar]
- Islam, R.; Hossain, M.N.; Alam, M.K.; Uddin, M.E.; Rony, M.H.; Imran, M.A.S.; Alam, M.F. Antibacterial activity of lactic acid bacteria and extraction of bacteriocin protein. Adv. Biosci. Biotechnol. 2020, 11, 49–59. [Google Scholar] [CrossRef]
- Awaisheh, S.S.; Ibrahim, S.A. Screening of antibacterial activity of lactic acid bacteria against different pathogens found in vacuum-packaged meat products. Foodborne Pathog. Dis. 2009, 6, 1125–1132. [Google Scholar] [CrossRef]
- Bukhari, S.A.; Salman, M.; Numan, M.; Javed, M.R.; Zubair, M.; Mustafa, G. Characterization of antifungal metabolites produced by Lactobacillus plantarum and Lactobacillus coryniformis isolated from rice rinsed water. Mol. Biol. Rep. 2020, 47, 1871–1881. [Google Scholar] [CrossRef]
- Torres, M.J.; Rocha, V.F.; Audisio, M.C. Laboratory evaluation of Lactobacillus johnsonii CRL 1647 metabolites for biological control of Musca domestica. Entomol. Exp. Appl. 2016, 159, 347–353. [Google Scholar] [CrossRef]
- Gupta, R.; Sarkar, S.; Srivastava, S. In vivo toxicity assessment of antimicrobial peptides (AMPs LR14) derived from Lactobacillus plantarum strain LR/14 in Drosophila melanogaster. Probiotics Antimicrob. Proteins 2014, 6, 59–67. [Google Scholar] [CrossRef]
- Colvin, D.; Dhuri, V.; Verma, H.; Lokhande, R.; Kale, A. Enterococcus durans with mosquito larvicidal toxicity against Culex quinquefasciatus, elucidated using a proteomic and metabolomic approach. Sci. Rep. 2020, 10, 4774. [Google Scholar] [CrossRef]
- Zheng, J.; Wittouck, S.; Salvetti, E.; Franz, C.M.; Harris, H.M.; Mattarelli, P.; O’toole, P.W.; Pot, B.; Vandamme, P.; Walter, J. A taxonomic note on the genus Lactobacillus: Description of 23 novel genera, emended description of the genus Lactobacillus Beijerinck 1901, and union of Lactobacillaceae and Leuconostocaceae. Int. J. Syst. Evol. Microbiol. 2020, 70, 2782–2858. [Google Scholar] [CrossRef]
- Mun, S.Y.; Kim, S.K.; Woo, E.R.; Chang, H.C. Purification and characterization of an antimicrobial compound produced by Lactobacillus plantarum EM showing both antifungal and antibacterial activities. LWT 2019, 114, 108403. [Google Scholar] [CrossRef]
- Chen, C.Y. Biosynthesis of di-(2-ethylhexyl) phthalate (DEHP) and di-n-butyl phthalate (DBP) from red alga—Bangia atropurpurea. Water Res. 2004, 38, 1014–1018. [Google Scholar] [CrossRef] [PubMed]
- El-Sayed, O.H.; Asker, M.; Shash, S.M.; Hamed, S.R. Isolation, structure elucidation and biological activity of Di-(2-ethylhexyl) phthalate produced by Penicillium janthinellum 62. Int. J. Chemtech Res. 2015, 8, 58–66. [Google Scholar]
- Kalinovskaya, N.I.; Romanenko, L.A.; Kalinovsky, A.I. Antibacterial low-molecular-weight compounds produced by the marine bacterium Rheinheimera japonica KMM 9513 T. Antonie Leeuwenhoek 2017, 110, 719–726. [Google Scholar] [CrossRef] [PubMed]
- Anju, K.; Archana, M.; Mohandas, C.; Nambisan, B. An antimicrobial phthalate derivative from Bacillus cereus, the symbiotic bacterium associated with a novel entomopathogenic nematode, Rhabditis (Oscheius) sp. Int. J. Pharm. Pharm. Sci. 2015, 7, 238–242. [Google Scholar]
- Lotfy, W.A.; Mostafa, S.W.; Adel, A.A.; Ghanem, K.M. Production of di-(2-ethylhexyl) phthalate by Bacillus subtilis AD35: Isolation, purification, characterization and biological activities. Microb. Pathog. 2018, 124, 89–100. [Google Scholar] [CrossRef] [PubMed]
- Lotfy, M.M.; Hassan, H.M.; Hetta, M.H.; El-Gendy, A.O.; Mohammed, R. Di-(2-ethylhexyl) phthalate, a major bioactive metabolite with antimicrobial and cytotoxic activity isolated from river Nile derived fungus Aspergillus awamori. Beni Suef Univ. J. Basic Appl. Sci. 2018, 7, 263–269. [Google Scholar] [CrossRef]
- Perveen, I.; Raza, M.A.; Iqbal, T.; Naz, I.; Sehar, S.; Ahmed, S. Isolation of anticancer and antimicrobial metabolites from Epicoccum nigrum; endophyte of Ferula sumbul. Microb. Pathog. 2017, 110, 214–224. [Google Scholar] [CrossRef]
- Roy, R.N.; Sen, S.K. Fermentation studies for the production of dibutyl phthalate, an ester bioactive compound from Streptomyces albidoflavus MTCC 3662 using low-priced substrates. Jordan J. Biol. Sci. 2013, 6, 177–181. [Google Scholar] [CrossRef]
- Pournejati, R.; Gust, R.; Sagasser, J.; Kircher, B.; Jöhrer, K.; Ghanbari, M.M.; Karbalaei-Heidari, H.R. In vitro evaluation of cytotoxic effects of di (2-ethylhexyl) phthalate (DEHP) produced by Bacillus velezensis strain RP137 isolated from Persian Gulf. Toxicol. In Vitro 2021, 73, 105148. [Google Scholar] [CrossRef]
- El-Sayed, M.H. Di-(2-ethylhexyl) phthalate, a major bioactive metabolite with antimicrobial and cytotoxic activity isolated from the culture filtrate of newly isolated soil Streptomyces (Streptomyces mirabilis strain NSQu-25). World Appl. Sci. J. 2012, 20, 1202–1212. [Google Scholar]
- Rajamanikyam, M.; Vadlapudi, V.; Parvathaneni, S.P.; Koude, D.; Sripadi, P.; Misra, S.; Amanchy, R.; Upadhyayula, S.M. Isolation and characterization of phthalates from Brevibacterium mcbrellneri that cause cytotoxicity and cell cycle arrest. EXCLI J. 2017, 16, 375. [Google Scholar] [PubMed]
- Rejiniemon, T.S.; Arasu, M.V.; Duraipandiyan, V.; Ponmurugan, K.; Al-Dhabi, N.A.; Arokiyaraj, S.; Agastian, P.; Choi, K.C. In-vitro antimicrobial, antibiofilm, cytotoxic, antifeedant and larvicidal properties of novel quinone isolated from Aegle marmelos (Linn.) Correa. Ann. Clin. Microbiol. Antimicrob. 2014, 13, 48. [Google Scholar] [CrossRef] [PubMed]
- Qi, S.H.; Xu, Y.; Xiong, H.R.; Qian, P.Y.; Zhang, S. Antifouling and antibacterial compounds from a marine fungus Cladosporium sp. F14. World J. Microbiol. Biotechnol. 2009, 25, 399. [Google Scholar] [CrossRef]
- Sarkar, A.; Bagavananthem Andavan, G.S. Computational optimization of in vitro parameters for di-(2-ethylhexyl) phthalate production from Anabaena circinalis. J. Cell. Biochem. 2019, 120, 790–798. [Google Scholar] [CrossRef]
- Lee, K.H.; Kim, J.H.; Lim, D.S.; Kim, C.H. Anti-leukaemic and anti-mutagenic effects of Di (2-ethylhexyl) phthalate isolated from Aloe vera Linne. J. Pharm. Pharmacol. 2000, 52, 593–598. [Google Scholar] [CrossRef]
- Uyeda, M.; Suzuki, K.; Shibata, M. 3315-AF2, a cell aggregation factor produced by Streptomyces sp. strain no. A-3315. Agric. Biol. Chem. 1990, 54, 251–252. [Google Scholar] [CrossRef]
- Hoang, V.L.; Li, Y.; Kim, S.K. Cathepsin B inhibitory activities of phthalates isolated from a marine Pseudomonas strain. Bioorg. Med. Chem. 2008, 18, 2083–2088. [Google Scholar] [CrossRef]
- Parappilly, S.J.; Idicula, D.V.; Chandran, A.; Mathil Radhakrishnan, K.; George, S.M. Antifungal activity of human gut lactic acid bacteria against aflatoxigenic Aspergillus flavus MTCC 2798 and their potential application as food biopreservative. J. Food Saf. 2021, 41, e12942. [Google Scholar] [CrossRef]
- Colovic, M.B.; Krstic, D.Z.; Lazarevic-Pasti, T.D.; Bondzic, A.M.; Vasic, V.M. Acetylcholinesterase inhibitors: Pharmacology and toxicology. Curr. Neuropharmacol. 2013, 11, 315–335. [Google Scholar] [CrossRef]
- Riaz, B.; Zahoor, M.K.; Zahoor, M.A.; Majeed, H.N.; Javed, I.; Ahmad, A.; Jabeen, F.; Zulhussnain, M.; Sultana, K. Toxicity, phytochemical composition, and enzyme inhibitory activities of some indigenous weed plant extracts in fruit fly, Drosophila melanogaster. Evid. Based Complement. Altern. Med. 2018, 2018, 2325659. [Google Scholar] [CrossRef] [PubMed]
- Ganesan, P.; Stalin, A.; Paulraj, M.G.; Balakrishna, K.; Ignacimuthu, S.; Al-Dhabi, N.A. Biocontrol and non-target effect of fractions and compound isolated from Streptomyces rimosus on the immature stages of filarial vector Culex quinquefasciatus Say (Diptera: Culicidae) and the compound interaction with Acetylcholinesterase (AChE1). Ecotoxicol. Environ. Saf. 2018, 161, 120–128. [Google Scholar] [CrossRef] [PubMed]
- Katade, S.R.; Pawar, P.V.; Tungikar, V.B.; Tambe, A.S.; Kalal, K.M.; Wakharkar, R.D.; Deshpande, N.R. Larvicidal activity of bis (2-ethylhexyl) benzene-1, 2-dicarboxylate from Sterculia guttata seeds against two mosquito species. Chem. Biodivers. 2006, 3, 49–53. [Google Scholar] [CrossRef] [PubMed]
- Zahoor, M.K.; Zahoor, M.A.; Mubarik, M.S.; Rizvi, H.; Majeed, H.N.; Zulhussnain, M.; Ranian, K.; Sultana, K.; Imran, M.; Qamer, S. Insecticidal, biological and biochemical response of Musca domestica (Diptera: Muscidae) to some indigenous weed plant extracts. Saudi J. Biol. Sci. 2020, 27, 106–116. [Google Scholar]
- Sattar, M.; Iqbal, M.N.; Ashraf, A.; Ali, S.; Shahzad, M.I.; Alam, S.; Ali, T.; Sheikh, R. Larvicidal efficacy of Citrus sinensis extracts against Culex quinquefasciatus. PSM Microbiol. 2016, 1, 56–61. [Google Scholar]
- Atalla, M.M.; Zeinab, H.K.; Eman, R.H.; Amani, A.Y.; Abeer, A. Production of some biologically active secondary metabolites from marine-derived fungus Varicosporina ramulosa. Malays. J. Microbiol. 2008, 4, 14–24. [Google Scholar]
- Zola, F.G.; Rodrigues, A.C.; Oliveira, B.D.Á.; Sacramento, N.T.B.; Taylor, J.G.; Pinto, U.M.; Bertoldi, M.C. Mineral and centesimal contents, antioxidant activity and antimicrobial action of phenolic compounds from Eugenia Brasiliensis Lam. Pulp. Food Sci. Technol. 2019, 39, 378–385. [Google Scholar] [CrossRef]
- Kumar, S.N.; Mohandas, C.; Nambisan, B. Purification of an antifungal compound, cyclo (L-Pro-D-Leu) for cereals produced by Bacillus cereus subsp. thuringiensis associated with entomopathogenic nematode. Microbiol. Res. 2013, 168, 278–288. [Google Scholar] [CrossRef]
- Capriotti, K.; Capriotti, J.A. Dimethyl sulfoxide: History, chemistry, and clinical utility in dermatology. J. Clin. Aesthet. Dermatol. 2012, 5, 24. [Google Scholar]
- Hemmalakshmi, S.; Priyanga, S.; Devaki, K. Fourier Transform Infra-Red Spectroscopy analysis of Erythrina variegata L. J. Pharm. Sci. Res. 2017, 9, 2062–2067. [Google Scholar]
- Mashima, I.; Miyakawa, H.; Scannapieco, F.A.; Nakazawa, F. Identification of an early stage biofilm inhibitor from Veillonella tobetsuensis. Anaerobe 2018, 52, 86–91. [Google Scholar] [CrossRef] [PubMed]
- WHO. Report of the WHO Informal Consultation on the Evaluation and Testing of Insecticides; World Health Organization: Geneva, Switzerland, 1996. [Google Scholar]
- Kumaravel, T.; Jha, A.N. Reliable Comet assay measurements for detecting DNA damage induced by ionising radiation and chemicals. Mutat. Res. Genet. Toxicol. Environ. Mutagen. 2006, 605, 7–16. [Google Scholar] [CrossRef] [PubMed]
- Abbott, W.S. A method of computing the effectiveness of an insecticide. J. Econ. Entomol. 1925, 18, 265–267. [Google Scholar] [CrossRef]
- Dua, V.K.; Kumar, A.; Pandey, A.C.; Kumar, S. Insecticidal and genotoxic activity of Psoralea corylifolia Linn.(Fabaceae) against Culex quinquefasciatus Say, 1823. Parasites Vectors 2013, 6, 30. [Google Scholar] [CrossRef] [PubMed]

| Sr. No. | Column Chromatography Mobile Phase Solvent of Bioactive Fraction | Metabolite Name | Molecular Formula | Molecular Mass |
|---|---|---|---|---|
| 1 | 85% chloroform in n-hexane | Bis-(2-ethylhexyl) phthalate (BEHP) | C24H38O4 | 390.564 g/mol |
| Exposure Time | BEHP Concentration (ppm) | |||||
|---|---|---|---|---|---|---|
| 0 (E.F.) | 50 | 100 | 150 | 200 | 250 | |
| Mortality % Age (Mean ± S.E.) | ||||||
| 24 h F = 84.30; d.f. = 5; p < 0.05 | 0.00 ± 0.00 a | 23.33 ± 3.33 b | 33.33 ± 1.66 bc | 43.33 ± 3.33 c | 55.00 ± 2.88 d | 61.66 ± 1.66 d |
| 48 h F = 138.75; d.f. = 5; p < 0.05 | 0.00 ± 0.00 a | 43.33 ± 3.33 b | 61.66 ± 1.66 c | 71.66 ± 1.66 cd | 76.66 ± 1.66 d | 78.33 ± 4.40 d |
| 72 h F = 241.13; d.f. = 5; p < 0.05 | 0.00 ± 0.00 a | 61.66 ± 1.66 b | 75.00 ± 2.88 c | 88.33 ± 4.40 d | 91.66 ± 1.66 de | 100 ± 0.00 e |
| Observation Interval (h) | N | LC50 (Lower ± Upper Value) | Slope ± S.E. | X2 | p-Value |
|---|---|---|---|---|---|
| 24 | 20 | 186.11 (169.86 ± 205.83) | 0.0071684 ± 0.0007120 | 17.55 | 0.002 |
| 48 | 20 | 108.66 (94.43 ± 122.00) | 0.0082078 ± 0.0007042 | 48.06 | 0.000 |
| 72 | 20 | 67.03 (56.82 ± 76.34) | 0.0144255 ± 0.0010709 | 54.91 | 0.000 |
| BEHP Concentration (ppm) | ||||
|---|---|---|---|---|
| 50 ppm | 100 ppm | 150 ppm | 200 ppm | 250 ppm |
| AChE (% inhibition) F = 476.01; d.f. = 4; p < 0.05 | ||||
| 29.00 ± 0.57 a | 40.33 ± 0.88 b | 53.00 ± 1.15 c | 64.00 ± 0.57 d | 75.33 ± 0.88 e |
| Comet Parameters and DNA Damage | BEHP Concentration (ppm) | |||
|---|---|---|---|---|
| Control | 100 ppm | 150 ppm | 250 ppm | |
| Mean ± S.E. | ||||
| Tail Length (µm) F = 32.68; d.f. = 3; p < 0.05 | 3.27 ± 1.32 a | 6.85 ± 0.34 b | 7.58 ± 0.67 c | 14.18 ± 0.28 d |
| Tail DNA (%) F = 31.23; d.f. = 3; p < 0.05 | 1.13 ± 0.67 a | 9.13 ± 0.67 b | 13.86 ± 0.23 c | 18.23 ± 0.06 d |
| Tail Movement (µm) F = 51.53; d.f. = 3; p < 0.05 | 0.11 ± 0.13 a | 3.26 ± 0.29 b | 12.45 ± 0.96 c | 14.68 ± 0.56 d |
| Comet Length (µm) F = 34.33; d.f. = 3; p < 0.05 | 8.32 ± 01.89 a | 15.36 ± 0.87 b | 17.05 ± 0.49 c | 20.62 ± 0.64 d |
| Head Length (µm) (F = 13.46); d.f. = 3; (p < 0.05) | 7.03 ± 0.78 a | 11.84 ± 0.31 b | 15.98 ± 0.39 c | 23.75 ± 0.27 d |
| Head DNA (%) (F = 34.91); d.f. = 3; (p < 0.05) | 94.72 ± 0.98 d | 54.56 ± 0.67 c | 46.64 ± 0.86 b | 39.19 ± 0.92 a |
Publisher’s Note: MDPI stays neutral with regard to jurisdictional claims in published maps and institutional affiliations. |
© 2022 by the authors. Licensee MDPI, Basel, Switzerland. This article is an open access article distributed under the terms and conditions of the Creative Commons Attribution (CC BY) license (https://creativecommons.org/licenses/by/4.0/).
Share and Cite
Javed, M.R.; Salman, M.; Tariq, A.; Tawab, A.; Zahoor, M.K.; Naheed, S.; Shahid, M.; Ijaz, A.; Ali, H. The Antibacterial and Larvicidal Potential of Bis-(2-Ethylhexyl) Phthalate from Lactiplantibacillus plantarum. Molecules 2022, 27, 7220. https://doi.org/10.3390/molecules27217220
Javed MR, Salman M, Tariq A, Tawab A, Zahoor MK, Naheed S, Shahid M, Ijaz A, Ali H. The Antibacterial and Larvicidal Potential of Bis-(2-Ethylhexyl) Phthalate from Lactiplantibacillus plantarum. Molecules. 2022; 27(21):7220. https://doi.org/10.3390/molecules27217220
Chicago/Turabian StyleJaved, Muhammad Rizwan, Mahwish Salman, Anam Tariq, Abdul Tawab, Muhammad Kashif Zahoor, Shazia Naheed, Misbah Shahid, Anam Ijaz, and Hazrat Ali. 2022. "The Antibacterial and Larvicidal Potential of Bis-(2-Ethylhexyl) Phthalate from Lactiplantibacillus plantarum" Molecules 27, no. 21: 7220. https://doi.org/10.3390/molecules27217220
APA StyleJaved, M. R., Salman, M., Tariq, A., Tawab, A., Zahoor, M. K., Naheed, S., Shahid, M., Ijaz, A., & Ali, H. (2022). The Antibacterial and Larvicidal Potential of Bis-(2-Ethylhexyl) Phthalate from Lactiplantibacillus plantarum. Molecules, 27(21), 7220. https://doi.org/10.3390/molecules27217220

